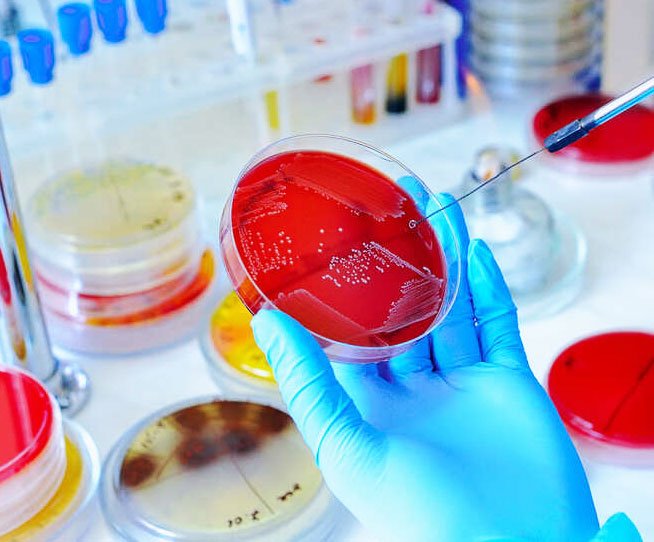

Spécialités médicales et analyses disponibles au Laboratoire Sidi Maarouf
Découvrez l’ensemble de nos examens biologiques réalisés au laboratoire. Nous mettons à votre disposition une variété d’analyses médicales pour accompagner vos besoins de dépistage, de suivi et de diagnostic, dans un cadre professionnel et sécurisé.
Analyses Disponibles :
- Analyses de sang complètes : pour surveiller votre santé globale dans un cadre préventif.
- Bilan de santé spécifique : suivi de diabète, suivi de grossesse etc.
- Tests allergiques : incluant les allergies alimentaires et respiratoires.
- Dépistage des MST.
- Prélèvements sanguins : effectués par notre équipe professionnelle directement sur place ou à domiciles.
- Test respiratoire à la recherche de l’Helicobacter pylori.
Hématologie

Immunologie – Sérologie


Endocrinologie – Hormonologie